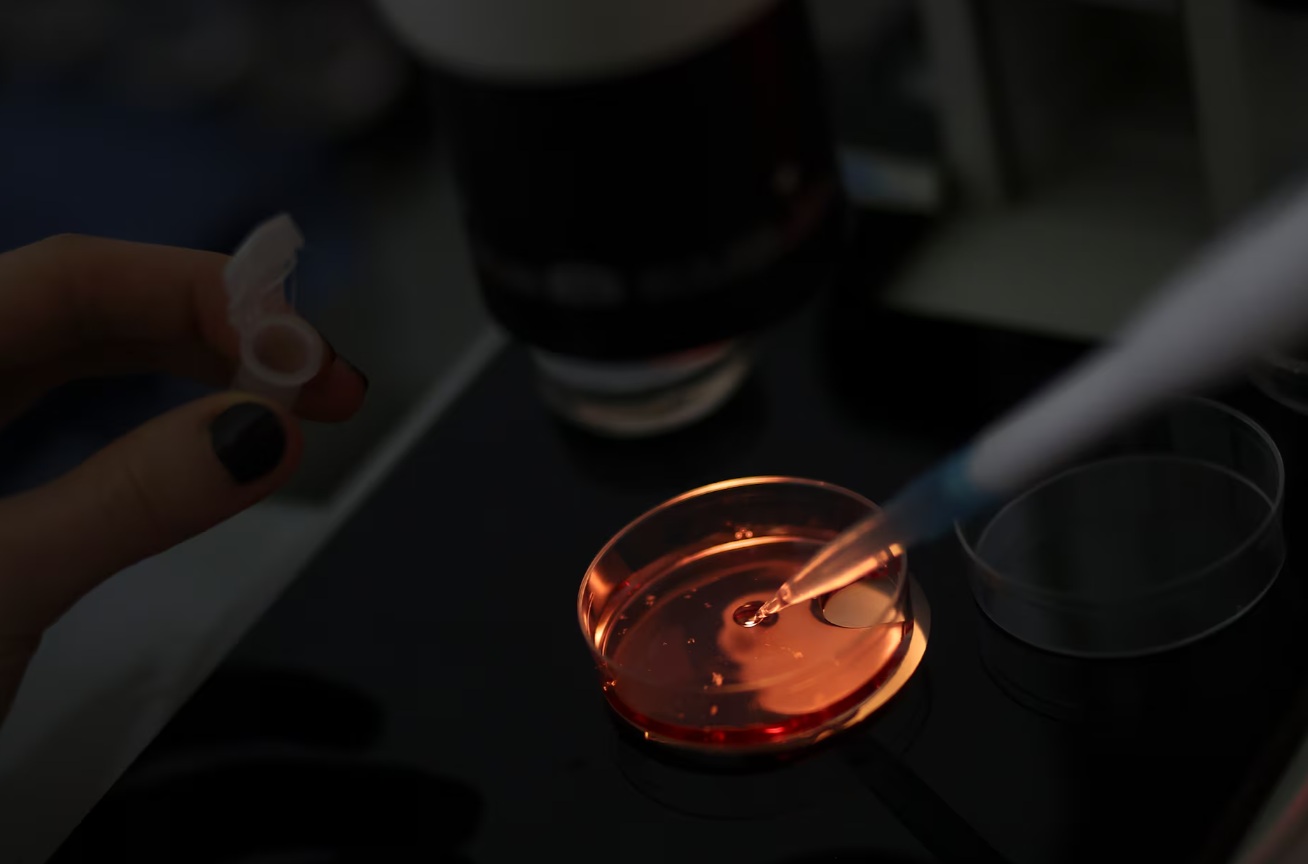

世界上第一批基因编辑马正在撼动马球这项优雅的运动
路透社
阿根廷被广泛认为是世界马球之都

阿根廷被广泛视为全球马球之都,一直以来都对克隆和其他育种创新持欢迎态度。但就目前而言,CRISPR 有所不同。
2025年7月29日,世界上首批基因编辑马在阿根廷布宜诺斯艾利斯圣安东尼奥·德阿雷科的围栏内飞奔。这些马天生速度惊人,去年年底出生。路透社/阿古斯汀·马尔卡里安
布宜诺斯艾利斯——它们看起来就像普通的小马驹一样,温顺,有着蜜棕色的皮毛和白色的脸部斑块,满足于在布宜诺斯艾利斯省农村的一片隔离牧场里度过它们的日子,咀嚼苜蓿。
但这五匹 10 个月大的马是世界上第一批经过基因编辑的马:它们是获奖马 Polo Pureza(或 Polo Purity)的克隆版,使用 CRISPR 技术插入单个 DNA 序列,目的是产生爆发性的速度。
培育出这些马的阿根廷公司 Kheiron Biotech 表示,基因编辑有可能彻底改变马匹的繁殖方式。
克隆可以创造出基因完全相同的副本,而 CRISPR 则充当一种基因剪刀,可以剪切和定制 DNA。
这家专门从事马匹克隆的公司利用CRISPR技术降低了限制肌肉生长的肌生长抑制素基因的表达,旨在增加能够进行强力运动的肌肉纤维,从而将马匹改造成短跑健将。
但马球运动却不允许他们这么快进入。
尽管阿根廷被视为全球马球之都,长期以来一直欢迎包括克隆在内的生殖技术来培育精英马匹,但这项运动的国家机构和育种协会却设置障碍,阻止转基因马匹参与比赛。
阿根廷马球协会已禁止转基因马参加比赛。
“我不希望他们打马球,”协会主席本杰明·阿拉亚说。“这会失去马球的魅力,失去育种的魔力。我喜欢选一匹母马,再选一匹公马,让它们杂交,然后希望结果会很好。”
阿根廷马球马饲养者协会向路透社透露,该协会将对这些马进行四到五年的监测,然后再决定是否将它们注册为阿根廷马球小马。
Kheiron表示,他们相信马球界最终会改变主意。“事实上,我对此并不太担心,”该公司科学总监Gabriel Vichera告诉路透社。“我认为,教育才是我们必须继续做的事情。”
目前尚不清楚这项运动的国家机构将如何执行禁令。阿根廷法规并未区分克隆马、基因工程马和传统繁殖的马,马球协会也是如此。
一些饲养者表示,虽然他们欣赏克隆技术有助于保存血统,但基因编辑太过头了,可能会威胁到他们的生意。
价值80万美元的克隆马
“这毁了马匹繁育者,”马匹繁育者、前职业马球运动员马科斯·埃吉(Marcos Heguy)说道。“这就像用人工智能画画一样。艺术家完蛋了。”
从 20 世纪 70 年代开始从事育种工作的爱德华多·拉莫斯 (Eduardo Ramos) 表示,育种者最初也对胚胎移植和克隆等其他生物技术进步持怀疑态度。
“科学技术会不断进步,”他说。“那些说不应该这样做的人是无法阻止它的。”
马球起源于中亚,由英国移民传入阿根廷,并于 1882 年在布宜诺斯艾利斯成立了第一个马球俱乐部。马球有点像马背上的曲棍球,两队各有四人,挥舞长木槌将球击入球门柱。
这项运动花费不菲——每场比赛,选手要骑乘多达十几匹马——而在阿根廷,富裕的土地所有者家庭传统上一直主导着这项运动。
根据政府数据,该国去年出口了约 2,400 匹马球马,阿根廷马球品种在英国女王杯和阿根廷公开赛等著名比赛中占据主导地位。
这项运动长期以来一直使用代孕动物来孕育马球赛马的胚胎。与赛马不同,马球允许克隆动物。
世界上第一匹克隆马诞生于2003年。被公认为世界顶级马球运动员的阿道夫·坎比亚索(Adolfo Cambiaso)推动了马球克隆技术的普及。2010年,坎比亚索的“夸特特拉”(Cuartetera)克隆马在一场拍卖会上以80万美元的价格售出,这一价格引起了当时还是生物技术博士生的维切拉(Vichera)的注意。
次年,在商人丹尼尔·萨马蒂诺(Daniel Sammartino)的支持下,维切拉与他人共同创立了Kheiron公司。该公司的第一匹克隆马于2013年诞生。
丹尼尔·萨马蒂诺是Kheiron Biotech公司的联合创始人,该公司研发了这些基因编辑的小马驹 ...

丹尼尔·萨马蒂诺是Kheiron Biotech公司的联合创始人,该公司研发了这些基因编辑的小马驹。他认为,这些小马驹可能会彻底改变精英马球马的培育方式——但目前业界对此仍持谨慎态度。路透社/阿古斯汀·马尔卡里安
克隆马起初并不容易销售。为了起步,萨马蒂诺表示,他向顶级繁育者提供免费克隆服务,作为交换,繁育者允许他保留一些新生的克隆马。该公司表示,到今年,他们将生产出400匹克隆马,根据繁育者协会的估计,这将占到2025年阿根廷所有克隆马出生数量的一半以上。
萨马蒂诺说,克隆马驹的平均售价为 4 万美元。
2017 年,Kheiron 实验室利用 CRISPR 基因编辑技术生产了九个转基因马胚胎用于研究目的。
当时主管该机构的马丁·莱马 (Martin Lema) 表示,这让阿根廷马球界的一些知名人士感到不安,他们拜访了政府的生物技术监管机构,担心基因编辑马匹进入这项运动的可能性。
克隆和基因编辑这项技术现在已经相当普及了。只要你能开张支票,就能搞定。
肯塔基大学格鲁克马研究中心遗传学家泰德·卡尔布弗莱施
凯隆表示,在接下来的几年里,实验室将专注于其他动物,生产用于人类移植的基因编辑牛和猪胚胎。
去年年底,在高乔小镇圣安东尼奥德阿雷科,农场工人仍然戴着贝雷帽,体现着传统牛仔文化,Kheiron 的生育诊所产下了五匹基因工程马驹。
Kheiron Biotech 公司的一名员工在位于布宜诺斯艾利斯皮拉尔的实验室里,对马匹正在发育的卵子或卵母细胞进 ...
Kheiron Biotech 公司的一名员工在位于布宜诺斯艾利斯皮拉尔的实验室里,对马匹正在发育的卵子或卵母细胞进行分类。路透社/Agustin Marcarian
计划暂停
据路透社查阅的一份政府文件显示,阿根廷生物技术监管机构已核实了此次DNA编辑。负责监管该机构的农业部拒绝置评。
阿根廷培育基因编辑马球超级小马
“我想养马,而不是骆驼”:匈牙利农民与“历史性”干旱作斗争
约有 50 名饲养者签署了一封致饲养者协会的信,信中称,基因编辑马“超越了界限”,并要求在“深刻思考我们想要走向何方”之前不要登记这些马。
尽管该协会主席圣地亚哥·巴列斯特 (Santiago Ballester) 表示,他个人对基因编辑马“没有意见”,但他承认,其他饲养者担心基因编辑会如何影响他们的业务,以及进口阿根廷马球马的国家是否会接受基因编辑马。
该协会决定谨慎行事。
“我们要小心谨慎,负责任,”巴列斯特说。“我们得看看这些马会造成什么影响,看看它们是不是真的优秀动物。如果它们很普通,谁来为此买单?”
肯塔基大学格鲁克马研究中心的遗传学家泰德·卡尔布弗莱施 (Ted Kalbfleisch) 表示,Kheiron 插入天然 DNA 序列只是加速了传统的修改过程,而传统的修改过程可能需要几代人的时间。
“当你试图进行一些你只能猜测的编辑时,事情就变得棘手了,”他说。但对于肌生长抑制素,科学家们编辑的是“一种我们已知存在于健康马匹中的基因。当他们取出这个基因并将其编辑成克隆体时,只要他们忠实地执行……它应该会起作用。”
尽管卡尔布弗莱施表示,基因编辑马在马球比赛中可能占有优势,但这并不一定是不公平的。
马球马通常在两岁时就开始适应,并在一两年后开始学习这项运动。但这些基因工程马的未来目前尚不确定 ...

马球马通常在两岁时就开始适应,并在一两年后开始学习这项运动。但这些基因工程马的未来目前尚不确定。路透社/阿古斯汀·马尔卡里安
“克隆和基因编辑这项技术现在已经相当普及了,”他说,“只要你能开张支票,就能搞定。”
这些马距离登上马球场还有很长的路要走。两岁时,它们会开始慢慢上马鞍。一两年后,它们就会开始学习马球。
但萨马蒂诺承认,他们的基因编辑服务商业化计划将暂停,直到马球管理部门同意为止。这一暂停令萨马蒂诺感到沮丧。他表示,阿根廷有十几位潜在的有意向的客户联系过他,但他以隐私原因为由拒绝让路透社与他们联系。
即便如此,萨马蒂诺承认仍然存在一些不确定因素。
“它会是一匹更好的马吗?我不知道。时间会证明一切。”
|